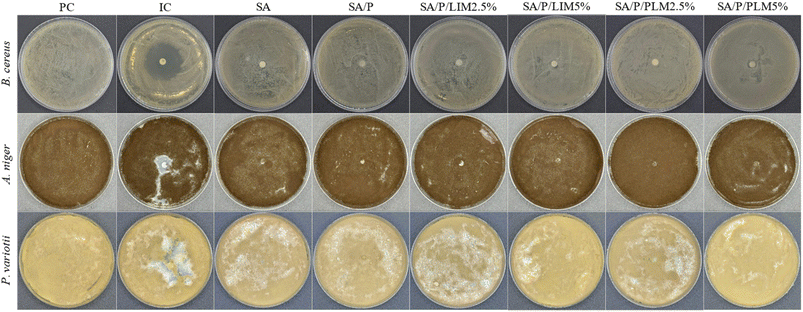
image file: d5fb00897b-f8.tif

Open Access Article
Open Access ArticleComparative study of sodium alginate films loaded with limonene and poly(limonene): interactions, properties, and functional activities
Matheus Milanez Leonettiab,
Vitor Emanuel de Souza Gomesa,
Guilherme Frey Schutzb,
Letícia Aliberti Galego Alves da Silvac,
Liliana de Oliveira Rochac,
Roniérik Pioli Vieirab and
Luís Marangoni Júnior *a
*a
aDepartment of Food Engineering and Technology, School of Food Engineering, University of Campinas, 13083-862 Campinas, Brazil. E-mail: luismj@unicamp.br
bDepartment of Materials and Bioprocess Engineering, School of Chemical Engineering, University of Campinas, 13083-852 Campinas, Brazil
cDepartment of Food Science and Nutrition, School of Food Engineering, University of Campinas, 13083-862 Campinas, Brazil
First published on 10th February 2026
Abstract
D-Limonene (LIM) is a terpene widely used as an additive in biopolymer-based active films, but its low thermal stability limits its applications. This study proposes using its thermally stable oligomer derivative, poly(limonene) (PLM), as an active component in sodium alginate (SA) films. PLM was synthesized via photopolymerization of LIM under mild conditions, yielding non-volatile oligomers with enhanced thermal stability. Scanning electron microscopy revealed a homogeneous surface distribution of the active oligomer in the films. Confirmatory analyses using Fourier-transform infrared spectroscopy and X-ray diffraction indicated reduced crystallinity after PLM incorporation. The addition of the active compounds did not significantly affect moisture content or water vapor permeability. While pure LIM exhibited inhibitory antimicrobial effects, none of the film solutions showed antimicrobial activity, likely due to low additive concentrations. Nonetheless, films with PLM demonstrated improved thermal stability and mechanical properties, with tensile strength increasing from 36 ± 3 MPa to 46 ± 5 MPa and elongation at break from 3.7 ± 0.8% to 14 ± 5% compared to the control films. Additionally, they presented a noticeable reduction in UV transmittance, indicating an improved UV light barrier. Films containing PLM also showed higher antioxidant activity than both the control and LIM films, with DPPH and ABTS scavenging effects of 7.8 ± 0.7% and 77 ± 16%, respectively. Overall, incorporating PLM is a promising strategy for utilizing citrus industry by-products, adding value to this natural compound while producing functional, biodegradable packaging materials with enhanced barrier and antioxidant features. Importantly, this work highlights the unexplored potential of PLM in SA films and provides new insights into how molecular structure affects film functionality. These advances contribute to the design of active packaging systems with improved stability and multifunctional performance.
Sustainability spotlightPackaging must be both circular and high-performing. We valorize a citrus by-product (D-limonene) by converting it via mild photopolymerization into poly(limonene) (PLM) and incorporating it into biodegradable sodium alginate films. Replacing volatile limonene with its oligomer enhances the material's thermal and mechanical properties, strengthens the UV-light barrier, and boosts antioxidant function without increasing moisture content or water vapor permeability. This molecular-design route upgrades renewable feedstocks into multifunctional materials, contributing to SDG 12 (Responsible Consumption and Production), SDG 9 (Industry, Innovation and Infrastructure), and SDG 13 (Climate Action). |
1 Introduction
Food packaging plays a crucial role in protecting products against external agents, preventing exposure to microorganisms, light radiation, gases, and humidity.1 To meet these requirements, synthetic polymer films are predominantly used due to their low permeability to gases and water vapor, favorable strength-to-weight ratio, flexibility, thermal stability, and economic viability.2,3 Owing to their unique characteristics, the packaging industry has seen a rising demand for fossil-based polymers, driving research towards more sustainable alternatives. These efforts primarily focus on creating materials from renewable sources that balance functionality and efficiency.Biopolymers stand out because of their renewable origin and biodegradability.4 The most studied biopolymers for packaging include proteins and polysaccharides such as pectin,5 chitosan,6,7 chitin,8,9 carrageenan,2 starch10,11 and sodium alginate,12 have also been widely investigated due to their film-forming ability. Sodium alginate (SA) is a polysaccharide extracted from brown seaweeds, characterized by a linear chain structure composed of repeating α-L-guluronic and β-D-mannuronic acid residues linked via α-1,4-glycosidic bonds.13 This versatile biopolymer has been extensively studied and applied across sectors such as pharmaceuticals,14 food industry,15 wastewater treatment,16 and tissue engineering.17 Its widespread application is due to its biocompatibility, biodegradability, non-toxicity, and high gelling capacity, making it a promising raw material for preparing films and coatings.3,13 However, despite these advantages, SA-based films present limitations, including low mechanical strength, high water vapor permeability, reduced thermal stability, and high water solubility.18
One strategy to overcome these limitations is the incorporation of bio-based active additives. This approach improves physical, chemical, and functional properties, making films more suitable for food packaging applications.19–22 Essential oils, in particular, have gained attention in recent years due to their contributions to food preservation and safety, while enhancing the physicochemical properties of the films.23,24 Studies highlight the potential of active SA films in food preservation by reducing oxidation, providing antimicrobial protection, and blocking UV radiation.25–28
D-Limonene (LIM) is a cyclic monoterpene found in the essential oils of various citrus plants, such as lemon, orange, sage, and bergamot.29,30 This compound is notable for its strong antioxidant and antimicrobial properties, which are vital for active packaging. LIM has been incorporated into different biopolymer films, including chitosan,6 poly(itaconic acid)/starch,11 poly(lactic acid),31 and pectin.5 However, its high volatility and thermal instability often lead to significant losses during film production and storage.32 Poly(limonene) (PLM), an oligomer obtained from LIM through radical photopolymerization, has emerged as an alternative.33 PLM exhibits higher thermal stability and lower volatility, while maintaining the bioactive properties of LIM. This makes it a more stable and effective additive for polymeric films, with the potential to overcome the limitations of monomeric LIM.7 Furthermore, PLM demonstrates biocompatibility with biomaterials and does not show cytotoxic effects at concentrations of up to 5%, indicating its suitability for biomedical and food applications within this threshold.11
In this context, the present study aimed to produce and comparatively characterize SA-based active films incorporated with LIM and PLM. The objective was to evaluate the effects of different proportions of these additives on the films' morphology, structure, and mechanical and thermal properties. We also analyzed the interactions between the polymer matrix and the additives. Additionally, the study sought to assess the films' effectiveness in antioxidant and antimicrobial activities. This allowed a comparative analysis of the performance of films containing LIM versus those incorporating PLM. By addressing the limited understanding of polymerized LIM in SA matrices, this work fills a clear research gap. It provides a comprehensive evaluation of both structural and functional properties. This approach contributes to the development of multifunctional active packaging materials and informs the selection of additives for improved film performance.
2 Materials and methods
2.1 Materials
Sodium alginate (SA, purity ≥99%, with a 61![[thin space (1/6-em)]](https://www.rsc.org/images/entities/char_2009.gif) :
:![[thin space (1/6-em)]](https://www.rsc.org/images/entities/char_2009.gif) 39 ratio of α-L-guluronic and β-D-mannuronic acids, respectively), D-limonene (LIM, purity ≥93%), N,N,N′,N″,N‴-pentamethyldiethylenetriamine (PMDETA, purity ≥99%), 2,2,2-tribromoethanol (TBE, purity ≥97%), benzophenone (BP, purity ≥99%), glycerol (GLI, purity ≥99%), and 2-[2-(2-hydroxyethoxy)propoxy]ethanol/Pluronic® F-127 (P, purity ≥99%) were purchased from Sigma-Aldrich (St. Louis, MO, USA). Dimethylacetamide (DMA, purity ≥99.5%) was bought from Vetec Química Fina Ltda. (Rio de Janeiro, RJ, Brazil).
39 ratio of α-L-guluronic and β-D-mannuronic acids, respectively), D-limonene (LIM, purity ≥93%), N,N,N′,N″,N‴-pentamethyldiethylenetriamine (PMDETA, purity ≥99%), 2,2,2-tribromoethanol (TBE, purity ≥97%), benzophenone (BP, purity ≥99%), glycerol (GLI, purity ≥99%), and 2-[2-(2-hydroxyethoxy)propoxy]ethanol/Pluronic® F-127 (P, purity ≥99%) were purchased from Sigma-Aldrich (St. Louis, MO, USA). Dimethylacetamide (DMA, purity ≥99.5%) was bought from Vetec Química Fina Ltda. (Rio de Janeiro, RJ, Brazil).
2.2 Synthesis of poly(limonene)
PLM was synthesized via a radical polymerization through photoinitiation, following the methodology adapted from Oliveira et al.33 and Santana et al.5 The reaction was carried out using LIM as the monomer, TBE as the initiator, benzophenone as the type II photoinitiator, and PMDETA as the electron-donating amine, in a molar ratio of 100![[thin space (1/6-em)]](https://www.rsc.org/images/entities/char_2009.gif) :
:![[thin space (1/6-em)]](https://www.rsc.org/images/entities/char_2009.gif) 1.7
1.7![[thin space (1/6-em)]](https://www.rsc.org/images/entities/char_2009.gif) :
:![[thin space (1/6-em)]](https://www.rsc.org/images/entities/char_2009.gif) 1.7
1.7![[thin space (1/6-em)]](https://www.rsc.org/images/entities/char_2009.gif) :
:![[thin space (1/6-em)]](https://www.rsc.org/images/entities/char_2009.gif) 8.5, respectively. DMA served as the solvent and the reaction mixture was prepared in glass flasks sealed with rubber septa and purged with nitrogen (N2) for 10 minutes under magnetic stirring to remove oxygen. Subsequently, the flasks were placed in a box with eight UV lamps to maintain approximately constant light exposure (at 365 nm and an intensity of 4 mW cm−2) for 6 hours at 40 °C. After the reaction, the resulting polymer was transferred to glass Petri dishes and dried in an oven at 45 °C for 48 hours to remove volatile components and residual monomer. Conversion was determined gravimetrically by comparing the polymer mass after reaction and dry steps to the initial monomer mass.
8.5, respectively. DMA served as the solvent and the reaction mixture was prepared in glass flasks sealed with rubber septa and purged with nitrogen (N2) for 10 minutes under magnetic stirring to remove oxygen. Subsequently, the flasks were placed in a box with eight UV lamps to maintain approximately constant light exposure (at 365 nm and an intensity of 4 mW cm−2) for 6 hours at 40 °C. After the reaction, the resulting polymer was transferred to glass Petri dishes and dried in an oven at 45 °C for 48 hours to remove volatile components and residual monomer. Conversion was determined gravimetrically by comparing the polymer mass after reaction and dry steps to the initial monomer mass.
2.3 Preparation of limonene and poly(limonene) emulsions
For the incorporation of LIM and PLM into the films, separate emulsions of these compounds were prepared using Pluronic® F127 as a surfactant. The emulsions were formulated with 1 g of Pluronic® in each 100 mL of distilled water, which was stirred until complete solubilization and then subjected to sonication for 5 minutes. Subsequently, the required amount of LIM or PLM was added to the emulsion to achieve the desired concentration for the films (2.5% w/w or 5% w/w relative to the SA). Emulsification was performed using an Ultra-Turrax homogenizer (model T25 digital, IKA®-Werke GmbH & Co. KG, Staufen, Germany) operating at 20000 rpm for 3 minutes. Finally, the emulsions were sonicated with a high-intensity ultrasound device (Q Sonica, model Q700, USA) and stored at 5 °C until use.2.4 Film preparation
The preparation of SA films was carried out using the casting method, as described in previous studies.34 The composition of each formulation is summarized in Table 1. In brief, a control film (SA) was prepared by dissolving SA (4% w/w) in distilled water, using glycerol (30% w/w relative to the biopolymer) as a plasticizer. The solution was homogenized with an Ultra-Turrax at 7000 rpm for 5 min. After complete dissolution, the SA solution was heated to 80 °C with continuous stirring for 15 min, followed by sonication under the same conditions to remove air bubbles. Subsequently, 50 g of the solution was poured into glass Petri dishes (145 mm diameter) and dried in an oven at 40 °C for 24 hours. For films containing LIM or PLM, the same procedure was applied, except that after heating, the solution was cooled to 40 °C before the addition of pre-prepared LIM or PLM emulsions. Final concentrations of 2.5% and 5% (w/w) were achieved in the film-forming dispersions. These mixtures were homogenized again using an Ultra-Turrax (7000 rpm for 5 minutes) before proceeding to the final casting and drying steps, as outlined for the control film. Additionally, control films containing only Pluronic® were prepared for comparison. After drying, the films were carefully removed from the dishes and stored at room temperature with controlled humidity.| Materials | SA | SA/P | SA/P/LIM2.5% | SA/P/LIM5% | SA/P/PLM2.5% | SA/P/PLM5% |
|---|---|---|---|---|---|---|
| Sodium alginate (SA) | 4.00 | 4.00 | 4.00 | 4.00 | 4.00 | 4.00 |
| Glycerol | 1.20 | 1.20 | 1.20 | 1.20 | 1.20 | 1.20 |
| Pluronic® (P) | — | 0.40 | 0.40 | 0.40 | 0.40 | 0.40 |
| Limonene (LIM) | — | — | 0.10 | 0.20 | — | — |
| Poly(limonene) (PLM) | — | — | — | — | 0.10 | 0.20 |
| Water | 94.80 | 94.40 | 94.30 | 94.20 | 94.30 | 94.20 |
2.5 Film characterization
 | (1) |
 | (2) |
To determine water vapor permeability (WVP), in triplicate for each formulation, the films were cut into circles with an area of 50 cm2, and the thickness of each sample was measured at 10 different points using a Mitutoyo Absolute digital comparator, model 543-450B (Mitutoyo Mexicana S.A. de C.V., Mexico), with a resolution of 1 µm. Subsequently, 25 g of anhydrous calcium chloride (PA) was placed into capsules, which were covered with the film, sealed with a silicone ring, and closed tightly. The capsules with the samples were then placed in a climate chamber (PROLAB, model SSCCU, São Paulo, Brazil) maintained at 25 °C and 75% relative humidity. At intervals of 1 hour, the capsules were removed, and their mass was measured using a precision analytical digital balance (Marte, model AY220, Minas Gerais, Brazil) with a resolution of 0.1 mg. The values of the water vapor transmission rate (WVTR) in g m−2 s−1 were obtained from the slope of the “mass increase × time” curve, according to the ASTM E96/E96M38 standard. Based on this, the WVP in g m−1 s−1 Pa−1 was calculated using eqn (3).
 | (3) |
The UV blocking efficiency, eqn (4), of the films was determined by integrating the spectral transmittance, T(λ) (%), across the corresponding wavelength ranges of UVC (200–280 nm), UVB (280–315 nm), and UVA (315–400 nm), assuming a uniform spectral weighting. The average transmittance for each band was calculated using the trapezoidal numerical integration method. For comparative purposes, a total UV blocking value (200–400 nm) was also computed. This approach provides a quantitative assessment of the film's ability to prevent UV radiation transmission across the different spectral regions.
 | (4) |
 | (5) |
Similarly to the DPPH assay, the antioxidant activity of the films was also evaluated using the ABTS radical cation scavenging activity. In triplicate, 15 mg of each formulation were incubated with 5 mL of aqueous ABTS solution for 1 hour at room temperature and in the absence of light. Absorbance measurements were taken with a UV-Vis spectrophotometer. The antioxidant activity (%) was calculated using eqn (6), where AbsABTS represents the absorbance of the ABTS solution and Absextract is the absorbance of the sample:
 | (6) |
The plates were prepared under three conditions: without any treatment (positive control, PC), in the presence of an antimicrobial agent (inhibition control, IC), and with the film-forming solutions of the formulations: SA, SA/P, SA/P/LIM 2.5%, SA/P/LIM 5%, SA/P/PLM 2.5%, and SA/P/PLM 5%. In the ICs, ciprofloxacin was used for B. cereus, and pure LIM (20 µL) for A. niger and P. variotii. For the other conditions, 20 µL of the respective film solution was deposited onto a sterile filter paper disc (6 mm diameter), placed at the center of each plate after microbial inoculation. The cultures were incubated at 30 °C for 24 hours for bacteria and at 25 °C for 7 days for fungi. After incubation, the plates were photographed for qualitative assessment of inhibition zones around the discs. All tests were performed in triplicate for the controls and each film formulation.
3. Results and discussion
3.1 Visual and morphological analysis by SEM
As observed in Fig. 1, overall, the SA films exhibited a uniform and homogeneous appearance, with no signs of pores or bubbles. The formulations SA, SA/P, SA/P/LIM2.5%, and SA/P/LIM5% appeared more translucent and colorless. Meanwhile, the films SA/P/PLM2.5% and SA/P/PLM5% showed a yellowish hue, attributed to the presence of PLM, with its intensity increasing proportionally to the concentration. The absence of macroscopic spots or heterogeneous regions suggested that PLM was homogeneously dispersed within the SA matrix at the evaluated concentrations.SEM images allow direct visualization of the films' microstructure, which strongly affects properties such as water vapor permeability and mechanical characteristics. The surface micrographs presented in Fig. 1 reinforced the films' predominantly uniform microstructure. However, particulate dispersions were visible, especially in the samples containing PLM, likely resulting from partially emulsified additive during film preparation.
The incorporation of LIM and PLM altered the surface morphology, creating cavities suggestive of successful incorporation of these additives. In the SA/P/PLM5% formulation, although the overall visual aspect remained uniform (Fig. 1k), a faint dark spot was identified on the surface micrograph. This may result from accumulated PLM, suggesting that its dispersion may have been less efficient at higher concentrations. In contrast, the SA/P/PLM2.5% formulation did not show such irregularities, corroborating previous findings on PLA/PBAT films with PLM.46
SEM images of the cross-sections (Fig. 1b, d, f, h, j and l) revealed the presence of some undissolved crystals, particularly in samples with LIM and PLM. This may be related to the hydrophobic nature of these compounds, which reduces their compatibility with hydrophilic biopolymers such as SA. Although such crystals have not been reported in other studies, the literature acknowledges the low compatibility of LIM and PLM with hydrophilic matrices.7,37 Microcracks and holes were observed mainly in the cross-section of films containing LIM, especially SA/P/LIM5%, likely resulting from the volatilization of the oil from the polymer matrix. This behavior has been previously reported by Schutz et al.37 and Toledo et al.46 For films with PLM, less pronounced surface porosity and indications of oil droplets were observed, particularly at higher concentrations. Earlier studies with PLM reported more intense visual spots on the surface than those observed in the present study.7,37 This reinforced that, despite occasional agglomerates, PLM achieved satisfactory homogeneity within the SA matrix. Overall, both surface holes and internal porosity detected in the cross-section suggest that LIM and PLM were dispersed as particles of various sizes throughout the film matrix.
3.2 Color analysis
The color of packaging materials can significantly influence consumer preferences and is associated with their ability to block visible and ultraviolet radiation, thereby aiding in the protection of photosensitive compounds. Table 2 summarizes the effects of incorporating LIM or PLM on the color parameters of SA-based films. Overall, films containing PLM exhibited significant changes (p < 0.05) compared to the other formulations. The chromatic coordinates a* and b* were significantly higher (p < 0.05) than those of the control and LIM-containing films, highlighting the characteristic yellowish hue associated with the oligomer. This observation has also been visually noted by Gonçalves et al.7 and Vianna et al.11 Brightness (L*) was also significantly reduced (p < 0.05) in the samples with PLM, due to their appearing more opaque and darker, which tended to hinder light transmission through the film.47 Finally, the overall color difference (ΔE) was significant (p < 0.05) between PLM films and the other formulations, especially at higher PLM concentrations, due to its inherent yellow coloration, as seen in Fig. 1.| Film | L* | a* | b* | ΔE |
|---|---|---|---|---|
| a L*: brightness; a*: green/red coordinate; b*: blue/yellow coordinate; ΔE: total color difference. Values are presented as mean ± standard deviation. Different letters (a–d) in the same column indicate a significant difference between samples according to the Tukey test (p < 0.05). | ||||
| SA | 89.48 ± 0.54a | 1.40 ± 0.17b | −0.46 ± 1.46d | 0.00 ± 0.00d |
| SA/P | 88.88 ± 0.85a | 1.41 ± 0.11b | 1.97 ± 2.09 cd | 3.16 ± 1.93 cd |
| SA/P/LIM2.5% | 89.46 ± 0.76a | 1.34 ± 0.07b | 2.58 ± 1.86c | 3.35 ± 2.11c |
| SA/P/LIM5% | 88.87 ± 0.54a | 1.36 ± 0.05b | 3.72 ± 1.28c | 4.37 ± 2.23c |
| SA/P/PLM2.5% | 85.67 ± 1.48b | 1.59 ± 0.25 ab | 11.91 ± 3.26b | 12.95 ± 4.13b |
| SA/P/PLM5% | 83.09 ± 1.93c | 1.79 ± 0.50a | 18.87 ± 4.05a | 20.37 ± 5.37a |
3.3 FT-IR and XRD analysis
FT-IR analysis was conducted to identify potential interactions between SA and the added active compounds (LIM and PLM). In all analyzed films (Fig. 2a), bands were observed around 3240 cm−1, 1596 cm−1, and 1407 cm−1, corresponding, respectively, to the hydroxyl group (–OH) and the asymmetric and symmetric vibrations of the carboxylate groups (–COO−). These bands are characteristic of the SA structure and have been reported in previous studies on this polysaccharide.48,49 No significant changes were detected in the spectra of films containing LIM and PLM compared to the control. This lack of alteration may be related to the low additive concentrations and to overlapping bands of SA and the additives themselves, as observed in other studies involving the addition of LIM or PLM in starch-based37 and chitosan-based films.6 | ||
| Fig. 2 FT-IR spectrum (a) and X-ray diffraction (XRD) profile (b) of the SA, SA/P, SA/P/LIM2.5%, SA/P/LIM5%, SA/P/PLM2.5%, and SA/P/PLM5% films. | ||
Nevertheless, a reduction in the intensity of the band associated with the hydroxyl group (around 3240 cm−1) was noticeable upon the addition of LIM and even more pronounced with PLM. This change was likely linked to a decrease in the number of free hydroxyl groups in the SA chains, possibly due to the hydrophobic nature of LIM and PLM, which restricts the exposure or interaction of these groups.7,50 Additionally, peaks near 842 cm−1 were observed, corresponding to the bending vibrations of the C–H bonds in the PLM ring. An increased intensity of the peak at 2888 cm−1 was also noted, attributed to the stretching vibrations of –CH and –CH2 groups in the chains of the surfactant Pluronic® F-127.51 Furthermore, a small peak around 1343 cm−1 appeared in the SA/P film, with its intensity increasing alongside the concentration of LIM and PLM. This band can be associated with the bending vibration of the O–H bond, characteristic of Pluronic® F-127, as previously reported in surfactant studies.51,52
Fig. 2b shows the diffractograms of the control films and those incorporated with LIM or PLM. The X-ray profiles indicate that all films exhibited a predominantly amorphous nature. Characteristic amorphous halos were observed at approximately 2θ ≈ 15.5° and 2θ ≈ 21.5°, which are typical of SA.48 The incorporation of LIM and PLM appeared to reduce the intensity of both halos, especially the one at 15.5°. These findings are consistent with the results reported for starch-based biocomposite films containing the same additives.37
3.4 Thermal stability of the films
Fig. 3 shows the TGA and DTG curves of the SA-based films. Table 3 presents the onset degradation temperature (Tonset), the maximum degradation temperature (Tmax), and the mass loss percentages for each thermal event identified in the analysis. Three thermal events were observed within the examined temperature range, except in the control SA formulation, which exhibited only the first two events. | ||
| Fig. 3 TGA (a) and DTG (b) curves for the films SA, SA/P, SA/P/LIM2.5%, SA/P/LIM5%, SA/P/PLM2.5%, and SA/P/PLM5%. | ||
| Film | 1st thermal event | 2nd thermal event | 3rd thermal event | ||||||
|---|---|---|---|---|---|---|---|---|---|
| Tonset (°C) | Tmax (°C) | Mass loss (%) | Tonset (°C) | Tmax (°C) | Mass loss (%) | Tonset (°C) | Tmax (°C) | Mass loss (%) | |
| SA | 65.54 | 100.39 | 14.184 | 240.66 | 248.29 | 47.250 | — | — | — |
| SA/P | 64.32 | 107.70 | 16.200 | 241.15 | 248.87 | 40.860 | 411.61 | 436.12 | 14.992 |
| SA/P/LIM2.5% | 67.83 | 108.43 | 14.768 | 239.72 | 247.70 | 41.291 | 413.09 | 436.85 | 15.700 |
| SA/P/LIM5% | 62.31 | 101.85 | 15.426 | 238.03 | 248.14 | 41.050 | 386.49 | 402.62 | 14.586 |
| SA/P/PLM2.5% | 70.39 | 102.43 | 14.734 | 238.40 | 247.85 | 41.764 | 417.20 | 435.39 | 15.490 |
| SA/P/PLM5% | 67.02 | 102.73 | 14.272 | 239.03 | 248.43 | 42.562 | 421.49 | 436.71 | 15.109 |
The first thermal event was similar across all formulations and was associated with the evaporation of moisture adsorbed within the films.48,53 This behavior is consistent with the moisture content (MC) values previously obtained (Fig. 4a). In addition to water, films containing LIM also exhibited evaporation of the terpene itself within the 50–120 °C range.6 The second event corresponded to the degradation of the SA polymer chains, primarily involving the cleavage of glycosidic bonds and decarboxylation of protonated carboxyl groups.48,54 Thermal degradation of incorporated glycerol also occurred during this interval.7 In formulations with PLM, degradation of the oligomer began at approximately 255 °C.11,46 The third event is likely related to the thermal decomposition of Pluronic® F-127, which generally occurs in the 350–420 °C range.55–57 This explains its absence in the control SA formulation.
During the second thermal event, Tmax values remained close to 248 °C across all formulations. However, a reduction of about 6% in mass loss was noted for the films containing LIM and PLM compared to the others. These results suggest a slight enhancement in thermal stability upon the incorporation of the additives, although no statistically significant differences were observed. Similar findings were reported by Gonçalves et al.,7 who observed improved thermal stability in chitosan films incorporated with PLM. Among the formulations tested, the SA/P sample displayed the lowest mass loss at this stage, with approximately a 6.5% reduction compared to the control SA film.
In the third thermal event, the Tonset values were higher for films containing PLM, with a trend of increasing Tonset corresponding to higher PLM concentrations. Tmax values remained at around 436 °C for nearly all samples. An exception was the SA/P/LIM5% sample, which exhibited a degradation peak at 402.62 °C, roughly 30 °C lower than the others. Overall, mass loss during this final event was relatively consistent across the formulations, ranging from 14.5% to 15.7%.
3.5 Moisture content (MC) and water vapor permeability (WVP)
According to the results shown in Fig. 4a, films containing LIM exhibited the lowest MC values among the analyzed samples. However, these reductions were not statistically significant (p > 0.05), as no formulation differed significantly from each other. The MC ranged from approximately 11% to 14%. Generally, the incorporation of terpenes such as LIM and its derivatives is expected to increase film hydrophobicity. This occurs because the additives reduce the availability of polar groups capable of interacting with water,6 which is expected to decrease the MC. In this context, the lack of a significant reduction may be attributed to the low concentrations of LIM and PLM used. This indicated that the amount of additive incorporated was insufficient to influence the film's hygroscopicity.Packaging films play a crucial role in protecting food by acting as barriers to moisture transfer. In this context, WVP is a key parameter for evaluating the efficiency of the material's hydrophobic barrier under specific thermal conditions.58 The WVP values, depicted in Fig. 4b, were slightly lower for formulations supplemented with LIM and PLM, including the SA/P sample. However, similar to the MC results, this reduction was not statistically significant (p > 0.05) at the concentrations tested. Reducing WVP is desirable in food packaging applications, as limiting moisture permeation between the product and the environment is fundamental for maintaining food quality.6,59 In this regard, hydrophobic compounds such as essential oils and their derivatives can decrease moisture permeation rates.60 This occurs by filling the spaces between polymer chains and increasing the tortuosity of the water vapor diffusion path.58 These findings highlight the potential of the tested additives, suggesting that higher concentrations could be explored to achieve more significant improvements in the barrier properties of SA-based films.
3.6 Film thickness
As shown in Fig. 5a, the average thickness of the SA and SA/P films was 103.2 ± 26.5 µm and 96.5 ± 10.2 µm, respectively. A slight increase in thickness was observed with the incorporation of LIM and PLM. However, these variations were not statistically significant (p > 0.05), possibly due to the low additive concentrations. Except for the SA/P/LIM5% sample, all other formulations containing the additives exhibited thickness values similar to the control film, ranging from approximately 100 to 110 µm. This increase in thickness could be associated with an expansion in the spacing between SA chains, likely caused by the intercalation of LIM and PLM molecules, which hampers the regular packing of the polymer matrix.6,113.7 Mechanical properties
Given the importance of good mechanical performance in coating films to ensure packaging integrity and durability,6 the results indicated that the incorporation of LIM and PLM at the evaluated concentrations (2.5% and 5%) did not negatively affect the films' mechanical properties, as shown in Fig. 5. The elastic modulus (EM), tensile strength (TS), and elongation at break (EB) for the SA films were 1572 ± 114 MPa, 36 ± 3 MPa, and 3.7 ± 0.8%, respectively. The SA/P films exhibited values of 1704 ± 349 MPa, 46 ± 3 MPa, and 7 ± 2%, respectively. Compared to the control films, EM showed no significant changes (p > 0.05) with increasing concentrations of LIM and PLM. This suggests that the films maintained their rigidity even after the addition of the active compounds (Fig. 5b).Regarding the TS (Fig. 5c), formulations containing lower concentrations of additives showed higher values than the SA film, but were similar to the SA/P film, around 45 MPa. The SA/P/PLM5% formulation did not differ significantly (p > 0.05) from any other formulation, with a TS of 38 ± 4 MPa, close to that of the SA film. Meanwhile, the SA/P/LIM5% formulation had the lowest TS among all samples (36 ± 8 MPa), being statistically similar (p > 0.05) only to SA/P/PLM5%. The EB values (Fig. 5d) for the SA/P/LIM2.5% and SA/P/PLM2.5% samples (13 ± 5% and 14 ± 5%, respectively) were significantly higher (p < 0.05) than that of the control SA film (3.7 ± 0.8%), despite the high variability in the data. The EB value for the SA/P/PLM5% formulation was 13 ± 2%, which was statistically higher (p < 0.05) than those of the SA and SA/P/LIM5% films, but similar (p > 0.05) to those of SA/P/LIM2.5% and SA/P/PLM2.5%.
These findings diverge from the general trend reported in the literature, where incorporating essential oils or their hydrophobic derivatives into polysaccharide-based films typically reduces TS. This reduction is generally due to the disruption of polymer–polymer interactions and phase separation, resulting in heterogeneous and mechanically weakened structures.60 Interestingly, in the present study, films containing Pluronic® F-127, whether combined with SA alone or in the presence of LIM or PLM, exhibited enhanced TS compared to the SA control. This suggests that the surfactant may play a structuring role, promoting better dispersion of hydrophobic compounds and reducing interfacial tension, thereby improving film homogeneity. Furthermore, in the case of PLM, the presence of polar terminal groups may have enabled secondary interactions, such as hydrogen bonding or dipole–dipole interactions, with the SA chains. This likely contributed to a more cohesive and reinforced network, as similarly observed by Gonçalves et al.7 in chitosan films.
The increase in EB values may be related to the plasticizing effect of essential oils, which enhances film flexibility.61,62 Additionally, Pluronic® F-127 may also have contributed to the increased TS and EB by promoting cohesion and adhesion between SA chains. Similar effects have been reported for polycaprolactone-based films, where Pluronic® improved their mechanical properties.63 In summary, based on TS and EB parameters, the films containing the additives demonstrated performance equal to or better than the control film, highlighting their potential for application as biodegradable packaging materials.
3.8 Light transmission
The transmittance spectra of the films (Fig. 6) and the quantitative UV-blocking data (Table 4) consistently demonstrate the superior light-shielding performance of PLM-incorporated formulations. Statistical analysis confirmed significant differences among all samples across the UVA, UVB, UVC, and total UV ranges. In the UVA region (315–400 nm), PLM films achieved the highest blocking efficiencies, 91.3 ± 1.0% for SA/P/PLM5% and 88.2 ± 3.2% for SA/P/PLM2.5%. These values were markedly higher than those of LIM films (77–79%) and far superior to the control matrices SA and SA/P (38.5% and 74.5%). The same trend was observed for UVB and UVC regions, where PLM films reached efficiencies above 95%, statistically surpassing all other samples. LIM-based films displayed intermediate behavior, while the control films exhibited the poorest performance, confirming the reinforcing role of both additives, especially PLM. | ||
| Fig. 6 Transmittance (%) graph as a function of wavelength (nm) for the films SA, SA/P, SA/P/LIM2.5%, SA/P/LIM5%, SA/P/PLM2.5%, and SA/P/PLM5%. | ||
| Film | UVA (%) | UVB (%) | UVC (%) | Total UV (%) |
|---|---|---|---|---|
| a Values are presented as mean ± standard deviation. Different letters (a–e) in the same column indicate a significant difference between samples according to the Tukey test (p < 0.05). | ||||
| SA | 38.5 ± 3.8c | 60.9 ± 5.4e | 88.1 ± 3.2d | 62.3 ± 3.9c |
| SA/P | 74.5 ± 0.4b | 83.1 ± 0.3d | 93.9 ± 0.4b | 83.8 ± 0.5b |
| SA/P/LIM2.5% | 78.6 ± 2.4b | 86.7 ± 1.7 cd | 96.0 ± 1.0b | 86.3 ± 3.0b |
| SA/P/LIM5% | 77.5 ± 5.3b | 85.6 ± 4.1c | 95.1 ± 1.8b | 85.5 ± 3.4b |
| SA/P/PLM2.5% | 88.2 ± 3.2 ab | 95.5 ± 0.8b | 99.4 ± 0.2a | 94.0 ± 1.4a |
| SA/P/PLM5% | 91.3 ± 1.0a | 98.6 ± 0.2a | 99.9 ± 0.0a | 95.5 ± 0.5a |
This promising UV light barrier performance can be attributed to the molecular structure of PLM, which is highly responsive to light absorption at shorter wavelengths. This behavior results from the preserved endocyclic π-bond originating from LIM during the polymerization process.7 Regardless of concentration, PLM films provided greater UV protection than LIM films. Their darker, opaque appearance likely also contributed to this effect, contrasting with the more translucent look of the LIM samples. These properties are crucial for packaging applications, as UV radiation accelerates oxidative processes in foods, especially in lipids, which can reduce nutritional quality and shelf life.64
In the visible range (400–800 nm), films with LIM and PLM also reduced light transmittance. In contrast, the control SA film presented higher transmittance. Film thickness, as shown in Fig. 5a, may have influenced these results. For instance, the SA/P/LIM5% formulation was the thickest among the analyzed films, which likely contributed to its improved light-blocking performance. Variations in thickness may affect the light barrier properties of the films.6
The UV barrier efficiency achieved with PLM incorporation is consistent with values reported for high-performance biopolymer-based films (Table 5). The near-complete blocking in the UVC/UVB region observed for the SA-based films is comparable to results obtained using carbon nanomaterials, modified biopolymers, and inorganic nanoparticles.65–69 In these systems, UV shielding efficiencies are remarkably high, which is generally attributed to the presence of aromatic or conjugated structures and/or inorganic nanoparticles. These components act as efficient UV absorbers and scattering centers, reducing light transmittance through electronic transitions, reflection, and multiple scattering of high-energy radiation.65–69
| Base material | UV agent | Transmittance at 280 nm | Transmittance at 600 nm | References |
|---|---|---|---|---|
| a For a fair comparison, the selected data from the literature65–69 correspond to formulations with additive concentrations similar to those used in this work (typically 1–10 wt%). The specific samples were chosen based on their optimized balance between maximum UV-blocking efficiency and maintaining adequate visible light transparency. | ||||
| Alginate | PLM | 0.7% | 44% | This work |
| Cellulose nanofiber | MXene | <1% | ∼58% | 65 |
| Chitin | Surface modification (Hantzsch reaction) | <1% | ∼88% | 66 |
| κ-carrageenan | Lignin | <1% | ∼60% | 67 |
| Gellan/Xanthan | ZnO | <1% | ∼70% | 68 |
| PVA/CNC | TiO2 | <1% | ∼7% | 69 |
Notably, while most high-performance barriers in Table 5 exhibit minimal transmittance in the UVB/UVC range, the films with PLM maintained a visible light transmittance of 44.2%. This is significantly higher than that observed for the TiO2 system.69 These findings indicate that PLM provides a light-shielding capability similar to conventional additives while maintaining moderate translucency in biopolymeric matrices.
3.9 Antioxidant activity
Fig. 7a illustrates the antioxidant activity of the films when in contact with the free radical DPPH. Incorporating antioxidant properties into food packaging materials is essential to maintain product quality and extend shelf life.70 The employed method is based on the neutralization of nitrogen-centered radicals of DPPH by hydrogen-donating antioxidant compounds. This reaction converts DPPH into its reduced form, DPPH-H.7The control formulations (SA and SA/P) and SA/P/LIM2.5% exhibited the lowest antioxidant activities, all below 4%. The best-performing films were SA/P/LIM5% and SA/P/PLM5%. Although SA/P/LIM5% did not differ significantly from the control SA (p > 0.05), the SA/P/PLM5% formulation showed a statistically higher activity (p < 0.05). When comparing films loaded with LIM and PLM at the same concentration, the results for PLM were higher, although not significantly different (p > 0.05). This trend may be related to the structure of PLM, which contains repeating LIM units with endocyclic double bonds that favor stabilization of DPPH radicals.7,11
The low concentration of PLM used, combined with an exposure time of only 30 minutes, may have limited the release of the active compound. This could explain the lack of significant differences observed. Previous studies with higher PLM concentrations in biopolymeric matrices, such as pectin5 and poly(itaconic acid)/starch,11 reported more pronounced antioxidant activities. Therefore, higher concentrations of PLM and/or longer contact times with radicals could enhance the antioxidant efficacy of the SA films, allowing sufficient time for active compound release.
In the ABTS assays, which are presented in Fig. 7b, films incorporated with PLM demonstrated excellent antioxidant activity. Control and LIM-based formulations showed activities between 10% and 30%. In contrast, SA/P/PLM2.5% and SA/P/PLM5% reached values close to 40% and 80%, respectively. These results indicate a significant difference (p < 0.05) between PLM and LIM in scavenging ABTS radicals. The better performance of PLM may be related to its higher thermal stability and lower volatility compared to LIM, which reduce the loss of active compounds through evaporation or degradation.7,46 Furthermore, SA/P/PLM5% performed significantly better (p < 0.05) than SA/P/PLM2.5%, suggesting that increasing the additive concentration directly enhances the films’ antioxidant activity.
In this assay, the films were exposed to ABTS radicals for 1 hour. This longer exposure likely provided enough time for the diffusion and release of active compounds into the medium, which may explain the superior antioxidant performance compared to the DPPH test. Additionally, the presence of the surfactant Pluronic® F-127 may also have contributed to this effect. Its hydrophilic poly(ethylene oxide) segments facilitate the formation and release of micelles containing the hydrophobic additives. This mechanism improves dispersion in the aqueous ABTS solution and increases the accessibility of antioxidant compounds to the radicals, thereby enhancing scavenging activity. These findings are consistent with previous results obtained from chitosan films containing LIM, where the influence of exposure time was similarly observed.6 Therefore, longer testing periods with DPPH could reveal even higher antioxidant activities in films with PLM at the studied concentrations.
3.10 Antimicrobial activity
The microbial culture plates with the tested microorganisms under different conditions are shown in Fig. 8. None of the evaluated formulations demonstrated antimicrobial activity, as evidenced by the absence of inhibition zones around the samples containing the film solutions. All formulations appeared visually similar to the positive control (PC). In contrast, the inhibition control (IC) showed clearly visible antimicrobial activity: the antibiotic inhibited B. cereus and pure LIM inhibited A. niger and P. variotii. The presence of inhibition zones around the samples in these controls confirms the sensitivity of the microorganisms to the free substances.Due to their hydrophobic nature, essential oils and their derivatives can interact with bacterial phospholipid membranes, causing structural damage, protein denaturation, and destabilization of enzymatic systems.6,60 Similarly, these compounds exhibit antifungal activity through multiple mechanisms, including membrane and cell wall disorganization, inhibition of chitin and ergosterol synthesis, and morphological alterations in hyphae. Essential oils may also impair mitochondrial function, reducing ATP production and increasing reactive oxygen species (ROS), which directly affects fungal growth and viability.71 Studies have further demonstrated the antimicrobial activity of PLM when incorporated into polymer matrices, inhibiting bacteria such as Staphylococcus aureus,5 Escherichia coli,46 Clostridium perfringens, Pseudomonas aeruginosa and B. cereus.11 For fungi, PLM showed activity against Colletotrichum gloeosporioides11 and A. niger.46 Comparable results have been described for citrus essential oils rich in LIM against species such as Aspergillus flavus, Penicillium verrucosum and Penicillium chrysogenum.72
In this context, the lack of antimicrobial activity in films containing LIM and PLM may be attributed to the low concentrations of additives used (2.5% and 5.0%). This explanation is consistent with previous studies that achieved antimicrobial effects using concentrations above 10% in various polymer matrices.5,46 Additionally, as shown in Fig. 8, pure LIM exhibited notable antifungal activity against the tested species. This suggests that the compound is indeed bioactive against fungi, provided that adequate concentrations are used.
Therefore, higher concentrations of LIM and PLM may be necessary to promote significant antimicrobial properties in SA-based films. These findings emphasize the importance of further studies to optimize formulation and incorporation methods, supporting the potential of terpenes and their derivates for active packaging applications in the food industry.
3.11 Economic and application perspectives of poly(limonene) synthesis
The photopolymerization of LIM is a relatively recent methodology, with most studies currently focused on laboratory-scale production. One of the main limitations for large-scale implementation is the relatively low monomer conversion and oligomer yield reported to date,33 which require further optimization in terms of reaction kinetics, photoinitiating systems, and reactor design.Although a detailed techno-economic assessment of the LIM photopolymerization pathway is still lacking, recent studies on LIM-derived polymers, particularly poly(limonene carbonate), have reported production costs comparable to fossil-based polymers (1.36–1.51 USD kg−1), such as polystyrene. These studies provide the most comprehensive economic data currently available for LIM-based materials. Importantly, they indicate that upstream processing steps, such as LIM extraction and oxidation, dominate the economic and environmental costs.73 This suggests that the polymerization step itself, including photopolymerization routes, may not represent the primary cost barrier. In this context, light-induced synthesis is particularly promising for industrial scaling, as it combines high process efficiency with low energy consumption and reduced operational costs.74,75 These features indicate that the photopolymerization pathway has the potential to be economically viable, especially when integrated with optimized upstream limonene production. Therefore, while the present methodology still requires further optimization, it offers competitive prospects for future scale-up scenarios.
From an application perspective, PLM synthesis represents an alternative strategy to conventional encapsulation techniques used to reduce the volatility of essential oils.5 While encapsulation approaches, such as those based on nanoparticle carriers or chemical crosslinking, often provide high loading capacity and controlled release properties, they typically involve multi-step processing and complex formulations.76 Specifically, when compared to alginate/collagen systems crosslinked with EDC/NHS reported for antimicrobial applications,77 the present approach offers advantages particularly relevant to food packaging applications.
Although EDC/NHS crosslinking is highly effective for developing stable nanocarriers in biomedical contexts, its use is often associated with relatively high reagent costs and the requirement for multi-stage processing, including strict pH control and subsequent purification steps.77 In contrast, the photopolymerization of LIM is a relatively simple process conducted under mild conditions, avoiding the need for specialized crosslinkers. Furthermore, the resulting PLM exhibits significantly lower volatility and improved thermal stability than its precursor monomer.11,33 Overall, this strategy aligns with current trends toward renewable and food-safe materials, offering a more straightforward and potentially scalable route for the development of active biodegradable packaging films.
4 Conclusions
The synthesis of PLM as a thermally more stable oligomer compared to LIM was successful, as was its incorporation into SA-based films. SEM images revealed a homogeneous surface distribution of the oligomer within the films, along with signs of terpene detachment from the polymer matrix. Visual and color analysis of the films confirmed an intensified yellow coloration in the active films containing PLM. FT-IR spectra showed a reduction in the hydroxyl band in the additive-containing samples. The addition of these active compounds also decreased the crystallinity of the films but slightly improved their thermal stability and mechanical properties. PLM-containing films exhibited higher tensile strength and flexibility compared to the control and LIM-containing films, reaching tensile strength values as high as 46 ± 5 MPa and an elongation at break of 14 ± 5%. The film-forming solutions of all tested formulations did not exhibit antimicrobial activity, likely due to the low concentrations of the additives used, even though the pure terpene demonstrated inhibitory effects against the tested microorganisms. Although reductions in moisture content and water vapor permeability were not statistically significant, these improvements suggest the functional potential of the additives, even at reduced concentrations. Finally, PLM enhanced the antioxidant and light barrier properties of the SA films, reaching values of 7.8 ± 0.7% DPPH scavenging, 77 ± 16% ABTS scavenging, and 95.5 ± 0.5% total UV blocking efficiency. These results surpassed those observed for its monomer, reinforcing its suitability for active, biodegradable packaging systems. Taken together, these findings go beyond the simple characterization of LIM and PLM in SA films. By directly comparing a volatile terpene with its more stable oligomeric derivative, this study addresses a clear research gap. It also provides new insight into how molecular structure influences the multifunctionality of active films. In doing so, it contributes to the development of more stable, effective, and sustainable packaging materials.Author contributions
M. M. Leonetti: formal analysis, investigation, data curation, writing – original draft, and visualization. V. E. de S. Gomes: formal analysis, investigation, and writing – review & editing; G. F. Schutz: formal analysis, investigation, and writing – review & editing; L. A. G. A. da Silva: formal analysis, investigation, and writing – review & editing; L. de O. Rocha: methodology, resources, and writing – review & editing; R. P. Vieira: methodology, validation, resources, and writing – review & editing; L. Marangoni Júnior: conceptualization, methodology, validation, resources, writing – review & editing, supervision, project administration, and funding acquisition.Conflicts of interest
The authors have nothing to declare.Data availability
The data will be made available upon request.Acknowledgements
This study was partly funded by the Coordination for the Improvement of Higher Education Personnel – Brazil (CAPES) – Financial Code 001. The authors would like to thank the Fundo de Apoio ao Ensino, Pesquisa e Extensão – FAEPEX of UNICAMP for the Early Career Grant No. 2978/24 and PIND No. 2519/25. Additionally, this study received partial financial support from the National Council for Scientific and Technological Development (CNPq), grant numbers 301184/2025-9 and 444408/2024-0. We acknowledge the support of the São Paulo Research Foundation (FAPESP) [Grant number 2022/02728-0, 2024/07891-2 and 2024/07555-2].References
- Jyoti, A. K. Gupta, A. Kumar and B. Kumar, Trends Food Sci. Technol., 2025, 163, 105148 CrossRef CAS.
- D. R. Adhika, G. Genecya, A. A. Habibah, A. N. A. R. Putri and U. S. F. Arrozi, OpenNano, 2025, 22, 100234 CrossRef CAS.
- M. Zhao, P. Han, H. Mu, S. Sun, J. Dong, J. Sun, S. Lu, Q. Wang and H. Ji, Food Chemistry: X, 2025, 25, 102174 CAS.
- T. F. Santos, C. M. Santos, H. J. Rao, M. R. Sanjay, J. H. O. Nascimento, D. F. S. Souza, F. Gapsari, R. Raharjo and S. Siengchin, Food Chem. Adv., 2025, 6, 100936 CrossRef.
- J. V. Santana, L. Marangoni Júnior, G. Z. Cassol, H. H. Sato and R. P. Vieira, Food Hydrocoll., 2024, 149, 109558 CrossRef CAS.
- M. H. R. Barbosa, S. d. Á. Gonçalves, L. Marangoni Júnior, R. M. V. Alves and R. P. Vieira, J. Food Meas. Char., 2022, 16, 2011–2023 CrossRef.
- S. d. Á. Gonçalves, M. H. R. Barbosa, L. Marangoni Júnior, R. M. V. Alves and R. P. Vieira, Food Packag. Shelf Life, 2023, 37, 101085 Search PubMed.
- F. N. Eze, T. J. Jayeoye, R. C. Eze and C. Ovatlarnporn, Int. J. Biol. Macromol., 2024, 255, 128073 CrossRef CAS.
- H. Zhu, S. Chen, J. Xue, X. Wang, T. Yang, J. He and Y. Luo, Int. J. Biol. Macromol., 2025, 297, 139762 CrossRef CAS PubMed.
- T. C. Vianna, C. O. Marinho, L. Marangoni Júnior, R. M. V. Alves, L. H. I. Mei, C. C. Tadini and R. P. Vieira, Waste Biomass Valoriz., 2023, 14, 3133–3145 CrossRef CAS.
- T. C. Vianna, S. d. Á. Gonçalves, L. Marangoni Júnior, R. M. V. Alves, V. T. Andrade, H. H. Sato and R. P. Vieira, ACS Sustain. Chem. Eng., 2024, 12, 8752–8764 CrossRef CAS.
- L. Marangoni Júnior, P. R. Rodrigues, E. Jamróz, R. G. da Silva, R. M. V. Alves and R. P. Vieira, J. Polym. Environ., 2023, 31, 1853–1865 CrossRef.
- M. Akbar, A. Yaqoob, A. Ahmad and R. Luque, Sodium Alginate-Based Nanomaterials for Wastewater Treatment, Elsevier, 2022, pp. 1–17 Search PubMed.
- N. M. Sanchez-Ballester, B. Bataille and I. Soulairol, Carbohydr. Polym., 2021, 270, 118399 CrossRef CAS.
- P. Yan, W. Lan and J. Xie, Trends Food Sci. Technol., 2024, 143, 104217 CrossRef CAS.
- V. U. Siddiqui, R. A. Ilyas, S. M. Sapuan, N. H. A. Hamid, P. S. Khoo, A. Chowdhury, M. S. N. Atikah, M. S. A. Rani and M. R. M. Asyraf, Int. J. Biol. Macromol., 2025, 298, 139946 Search PubMed.
- E. M. Hia, I. W. Suh, S. R. Jang and C. H. Park, Carbohydr. Polym., 2024, 346, 122666 CrossRef CAS.
- R. Priyadarshi, S. Roy, T. Ghosh, D. Biswas and J. W. Rhim, Sustainable Mater. Technol., 2022, 32, e00353 CrossRef CAS.
- K. Ma, F. Li, T. Zhe, X. Sun, X. Zhang, P. Wan, H. Na, J. Zhao and L. Wang, Food Chem., 2024, 435, 137552 CrossRef CAS.
- H. Baishya and S. Kumar, Trends Food Sci. Technol., 2025, 161, 105042 CrossRef CAS.
- H. Xiaowei, Z. Wanying, Z. Ke, S. Jiyong, Z. Xiaodong, Z. Junjun, S. Tingting, L. Hongcheng, L. Tao, Z. Xiaobo and L. Zhihua, Int. J. Biol. Macromol., 2025, 318, 145227 Search PubMed.
- M. Kashiri, Appl. Food Res., 2025, 101051 CrossRef CAS.
- S. Sharma, S. Barkauskaite, A. K. Jaiswal and S. Jaiswal, Food Chem., 2021, 343, 128403 CrossRef CAS PubMed.
- T. C. Vianna, C. O. Marinho, L. Marangoni Júnior, S. A. Ibrahim and R. P. Vieira, Int. J. Biol. Macromol., 2021, 182, 1803–1819 CrossRef CAS.
- O. L. Orhotohwo, P. Lucci, L. Aquilanti, A. K. Jaiswal, D. Pacetti and S. Jaiswal, LWT, 2025, 226, 117960 CrossRef CAS.
- L. Mao, Z. Dong, F. Dong, X. Dai and Z. Cao, Int. J. Biol. Macromol., 2025, 296, 139738 Search PubMed.
- Q. Liang, P. Cao, H. Lu, Y. Du, L. Kang, H. Ma and X. Ren, Int. J. Biol. Macromol., 2025, 315, 144268 CrossRef CAS PubMed.
- W. Y. Tong, A. R. Ahmad Rafiee, C. R. Leong, W.-N. Tan, D. J. Dailin, Z. M. Almarhoon, M. Shelkh, A. Nawaz and L. F. Chuah, Chemosphere, 2023, 336, 139212 Search PubMed.
- P. F. Onyekere, D. O. Nnamani, C. O. Peculiar-Onyekere and P. F. Uzor, Green sustainable process for chemical and environmental engineering and science: plant-derived green solvents: properties and applications, Elsevier, 2020, pp. 219–227 Search PubMed.
- M. Bacanli, A. A. Başaran and N. Başaran, Polyphenols: prevention and treatment of human disease, Elsevier, 2018, pp. 419–424 Search PubMed.
- E. Fortunati, F. Luzi, D. Puglia, F. Dominici, C. Santulli, J. M. Kenny and L. Torre, Eur. Polym. J., 2014, 56, 77–91 CrossRef CAS.
- H. C. Pan and S. Polat, Ind. Crops Prod., 2023, 204, 117308 Search PubMed.
- E. R. M. de Oliveira and R. P. Vieira, J. Polym. Environ., 2020, 28, 2931–2938 Search PubMed.
- L. Marangoni Júnior, R. G. da Silva, C. A. R. Anjos, R. P. Vieira and R. M. V. Alves, Carbohydr. Polym., 2021, 269, 118286 CrossRef.
- G. Simon Maia, G. Ferreira Toledo, G. Frey Schütz, L. Marangoni Júnior and R. Pioli Vieira, Int. J. Biol. Macromol., 2025, 319, 145710 Search PubMed.
- L. Kang, Q. Liang, H. Chen, Q. Zhou, Z. Chi, A. Rashid, H. Ma and X. Ren, Food Chem., 2023, 402, 134237 Search PubMed.
- G. F. Schutz, R. M. V. Alves, C. Delarmelina, M. C. T. Duarte and R. P. Vieira, Int. J. Biol. Macromol., 2024, 260, 129482 CrossRef CAS.
- ASTM International, 2022, DOI:10.1520/E0096_E0096M-22.
- International Organization for Standardization, Plastics—film and sheeting—determination of thickness by mechanical scanning, Geneva, 1993 Search PubMed.
- ASTM-D882, 2018, preprint.
- ASTM International, 2022, DOI:10.1520/E1348-22.
- B. Akachat, L. Himed, M. Salah, M. D'Elia, L. Rastrelli and M. Barkat, Foods, 2025, 14, 353 CrossRef CAS.
- J. Jovanovic, V. F. M. Ornelis, A. Madder and A. Rajkovic, Compr. Rev. Food Sci. Food Saf., 2021, 20, 3719–3761 CrossRef CAS PubMed.
- T. van den Brule, M. Punt, W. Teertstra, J. Houbraken, H. Wösten and J. Dijksterhuis, Environ. Microbiol., 2020, 22, 986–999 Search PubMed.
- M. Ijadpanahsaravi, L. B. Snoek, W. R. Teertstra and H. A. B. Wösten, Int. J. Food Microbiol., 2024, 410, 110495 CrossRef CAS PubMed.
- G. F. Toledo, G. F. Schutz, L. Marangoni Júnior and R. P. Vieira, Sustain. Mater. Technol., 2024, 41, e011099 Search PubMed.
- X. Dang, S. Han, Y. Du, Y. Fei, B. Guo and X. Wang, Food Chem., 2025, 466, 142192 Search PubMed.
- L. Marangoni Júnior, E. Jamróz, S. de Á. Gonçalves, R. G. da Silva, R. M. V. Alves and R. P. Vieira, Food Hydrocolloids Health, 2022, 100094, DOI:10.1016/j.fhfh.2022.100094.
- H. Wang, M. Li, R. Ren, Z. Gao, L. Meng, Z. Li and C. Cao, Carbohydr. Polym., 2025, 123430, DOI:10.1016/j.carbpol.2025.123430.
- U. Siripatrawan and W. Vitchayakitti, Food Hydrocoll., 2016, 61, 695–702 Search PubMed.
- P. Jegajeevanram, P. K. Abhilash, P. Gayathri, M. Abdur Rahman, N. Manikandan and P. Arulselvan, Inorg. Chem. Commun., 2024, 113247, DOI:10.1016/j.inoche.2024.113247.
- P. Kumari, V. Kant and M. Ahuja, J. Drug Deliv. Sci. Technol., 2024, 105451, DOI:10.1016/j.jddst.2024.105451.
- M. Younis, R. M. Kamel, A. Alhamdan, E. E. Fadly, A. I. Zein El-Abedein and M. N. Saleh, Int. J. Biol. Macromol., 2025, 143058, DOI:10.1016/j.ijbiomac.2025.143058.
- J. Lv, P. Chen and P. Li, Int. J. Biol. Macromol., 2025, 144370 CrossRef CAS.
- S. Tanaka, A. Doi, N. Nakatani, Y. Katayama and Y. Miyake, Carbon, 2009, 47, 2688–2698 Search PubMed.
- E. Kinnertová, T. Zelenka, G. Zelenková, L. Kořená, V. Slovák and M. Almáši, Carbon Trends, 2024, 17, 100401 CrossRef.
- N. T. Nguyen, V. T. Nguyen, T. T. Vu, T. V. Le Nguyen, T. T. T. Nguyen, P. D. Huynh, B. A. Pham, N. Q. Tran, D. T. Nguyen and P. Le Thi, Macromol. Res., 2024, 32, 427–442 Search PubMed.
- J. Long, W. Zhang, M. Zhao and C.-Q. Ruan, Carbohydr. Polym., 2023, 321, 121267 Search PubMed.
- Y. Li, C. Tang and Q. He, Food Biosci., 2021, 41, 100927 Search PubMed.
- L. Atarés and A. Chiralt, Trends Food Sci. Technol., 2016, 48, 51–62 CrossRef.
- J. Criollo-Feijoo, V. Salas-Gomez, F. Cornejo, R. Auras and R. Salazar, Heliyon, 2024, 10, e36150 CrossRef CAS.
- G. S. Lemos, J. S. Vitoria, L. M. Fonseca, J. B. Pires, F. T. da Silva, T. J. Siebeneichler, C. d. O. Pacheco, E. A. Gandra and E. d. R. Zavareze, Int. J. Biol. Macromol., 2025, 310, 143441 Search PubMed.
- A. Tenorio-Alfonso, E. Vázquez Ramos, I. Martínez, M. Ambrosi and M. Raudino, J. Mech. Behav. Biomed. Mater., 2023, 139, 105668 CrossRef PubMed.
- M. Alizadeh Sani, A. Khezerlou, M. Tavassoli, A. H. Abedini and D. J. McClements, Trends Food Sci. Technol., 2024, 145, 104366 CrossRef.
- M. He, Y. Huang, X. Zhang, W. Zhu, W. Shao, J. Wang, D. Xu and W. Yao, Int. J. Biol. Macromol., 2024, 130821, DOI:10.1016/j.ijbiomac.2024.130821.
- R. He, X. Wang, P. Chen, M. He and H. Qi, Int. J. Biol. Macromol., 2024, 138170, DOI:10.1016/j.ijbiomac.2024.138170.
- B. Rukmanikrishnan, S. K. Rajasekharan, J. Lee, S. Ramalingam and J. Lee, Mater. Today Commun., 2020, 24, 101346 CrossRef.
- B. Rukmanikrishnan, F. R. M. Ismail, R. K. Manoharan, S. S. Kim and J. Lee, Int. J. Biol. Macromol., 2020, 148, 1182–1189 CrossRef.
- S. Van Nguyen and B.-K. Lee, Carbohydr. Polym., 2022, 298, 120064 Search PubMed.
- X. Dang, S. Han and X. Wang, J. Colloid Interface Sci., 2025, 694, 137698 Search PubMed.
- F. Nazzaro, F. Fratianni, R. Coppola and V. De Feo, Pharmaceuticals, 2017, 10, 86 CrossRef.
- M. Viuda-Martos, Y. Ruiz-Navajas, J. Fernández-López and J. Pérez-Álvarez, Food Control, 2008, 19, 1130–1138 CrossRef.
- M. T. Bertão and R. P. Vieira, ACS Polym. Au, 2026 DOI:10.1021/acspolymersau.5c00192.
- D. Czachor-Jadacka and B. Pilch-Pitera, Prog. Org. Coat., 2021, 158, 106355 CrossRef.
- Y. Ji, C. Zhang, X. Xu, J. Zhao, J. Liu and Y. Huo, Small, 2025, 21, e09388 CrossRef.
- D. R. Reis, A. Ambrosi and M. Di Luccio, Future Foods, 2022, 5, 100126 CrossRef.
- F. S. G. T. Valookolaei, H. Sazegar and L. Rouhi, BMC Biotechnol., 2024, 24, 86 CrossRef PubMed.
| This journal is © The Royal Society of Chemistry 2026 |